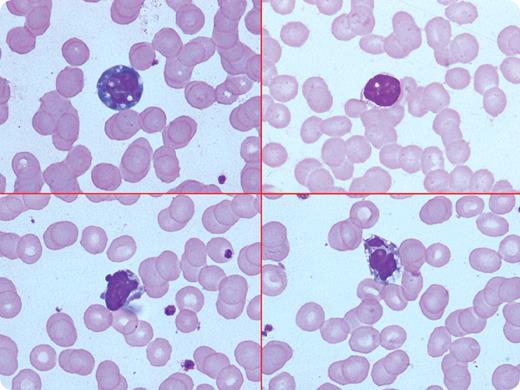

A 26-year-old woman had a 4-day history of fever, aches, and throat irritation. She had tender right posterior cervical lymphadenopathy and mild hepatosplenomegaly. Her hemoglobin was 12.6 g/dL, white blood count 5.5 × 109/L with relative lymphocytosis (58%), and platelet count 100 × 109/L. The peripheral smear showed reactive lymphocytes with rare (1%) apoptotic lymphocytes (top left panel shows apoptosis with nuclear condensation and bleb; top right, with nuclear condensation only; bottom left, with bleb formation; and bottom right, with nuclear fragmentation). Liver function tests were moderately abnormal. Malarial parasite, dengue, blood culture, viral hepatitis markers, and Widal were negative. The frequency of apoptotic lymphocytes increased to approximately 10% by the fifth day. Infectious mononucleosis was considered, but a monospot test was negative. The patient was treated symptomatically. The fever persisted, and a repeat peripheral smear still showed reactive lymphocytes with occasional apoptosis. A test for EBV IgM was positive (30U/mL, range: < 8), confirming the diagnosis of infectious mononucleosis.
Apoptosis of lymphocytes may appear as cell shrinkage, nuclear pyknosis and fragmentation, and nuclear blebs. When present, these changes can be seen in lymphoid malignancies, with chemotherapy, diabetes mellitus, connective tissue diseases, and HIV. In an appropriate clinical setting, apoptosis along with reactive lymphocytes is a strong clue for viral infection, such as infectious mononucleosis.
A 26-year-old woman had a 4-day history of fever, aches, and throat irritation. She had tender right posterior cervical lymphadenopathy and mild hepatosplenomegaly. Her hemoglobin was 12.6 g/dL, white blood count 5.5 × 109/L with relative lymphocytosis (58%), and platelet count 100 × 109/L. The peripheral smear showed reactive lymphocytes with rare (1%) apoptotic lymphocytes (top left panel shows apoptosis with nuclear condensation and bleb; top right, with nuclear condensation only; bottom left, with bleb formation; and bottom right, with nuclear fragmentation). Liver function tests were moderately abnormal. Malarial parasite, dengue, blood culture, viral hepatitis markers, and Widal were negative. The frequency of apoptotic lymphocytes increased to approximately 10% by the fifth day. Infectious mononucleosis was considered, but a monospot test was negative. The patient was treated symptomatically. The fever persisted, and a repeat peripheral smear still showed reactive lymphocytes with occasional apoptosis. A test for EBV IgM was positive (30U/mL, range: < 8), confirming the diagnosis of infectious mononucleosis.
Apoptosis of lymphocytes may appear as cell shrinkage, nuclear pyknosis and fragmentation, and nuclear blebs. When present, these changes can be seen in lymphoid malignancies, with chemotherapy, diabetes mellitus, connective tissue diseases, and HIV. In an appropriate clinical setting, apoptosis along with reactive lymphocytes is a strong clue for viral infection, such as infectious mononucleosis.
For additional images, visit the ASH IMAGE BANK, a reference and teaching tool that is continually updated with new atlas and case study images. For more information visit http://imagebank.hematology.org.
This feature is available to Subscribers Only
Sign In or Create an Account Close Modal